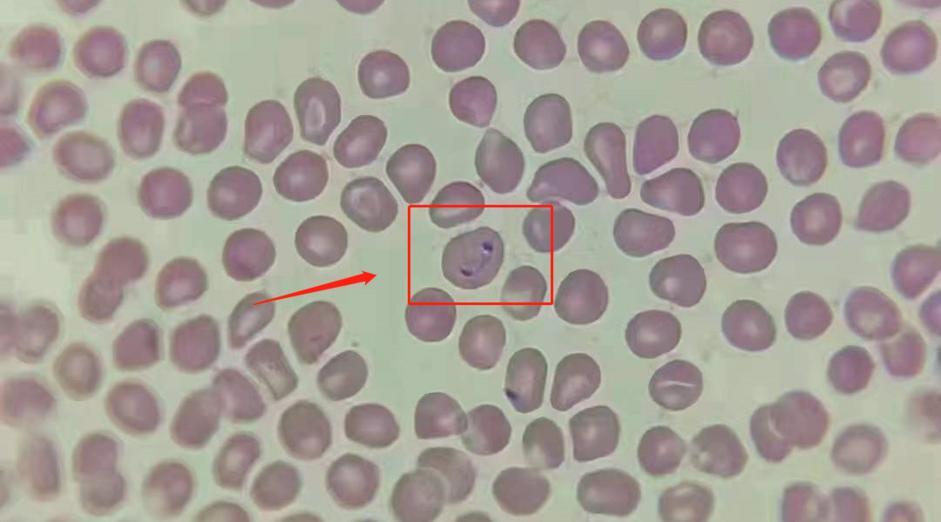
寄生虫感染严重的狗狗,狗狗巴贝斯虫生病了临死的征兆

你以为狗狗贫血只是营养不良导致的吗?并不是,寄生虫感染也会导致贫血。究竟是什么样的寄生虫,危害如此之大。

有相关数据显示:在蜱虫活跃的季节,经常外出的狗狗中,每7只就有1只可能被巴贝斯虫感染。
犬巴贝斯虫
巴贝斯虫,俗称焦虫。犬巴贝斯虫病是世界范围性疾病,目前感染犬的巴贝斯虫包括9种基因,犬属巴贝斯虫、吉氏巴贝斯虫、罗氏巴贝斯虫和伏氏巴贝斯虫等。 在中国地区优势虫种为吉氏巴贝斯虫。

传播途径
巴贝斯主要通过传播媒介蜱虫叮咬进行间接传播。在蜱虫叮咬过程中,从唾液腺释放子孢子进入宿主血液中,子孢子首先附着于红细胞表面,通过内吞作用进入红细胞内。蜱虫摄入感染的红细胞,在蜱虫的肠道内,巴贝斯进行有性繁殖。此外,被感染的动物之间也可以进行血液的直接传播。

(图片源于网络/侵删)
临床症状
临床症状具有多样性。包括发热、血小板减少症、溶血性贫血和脾肿大。经常会出现一些非特异性症状,如嗜睡、食欲不振和虚弱,黏膜黄疸或苍白,粘液颜色等。严重会出现并发症,如急性肾衰、凝血障碍、肝肿大、低血压、心脏疾病、急性胰腺炎等。
症状表现:无尿或少尿,运动失调,肌肉、眼球震颤,四肢划水样、攻击性增强、可能出现DIC、低氧导致肝细胞广泛性肿胀、呼吸窘等。

诊断方法
临床实验室检查、特殊诊断方法(显微镜观察、血清学检测和核酸检查方法)、病理学检查。
但目前任何治疗方法均不能完全消除虫体,治疗后也会有存在复发的可能,需要定期复查血常规。
(福懋宠物医院血涂片检查发现存在原虫) 预防
预防感染尤其重要。最重要的预防方式是传播媒介蜱虫进行控制。定期驱虫和经常检查犬皮毛和皮肤很重要,因为蜱虫可能至少需要吸血2天到3天方可传播寄生虫。
新宠进入家庭的之前需要进行检测、治疗和隔离观察,局部用药有助于控制蜱虫。

虽然说现在冬天不是蜱虫活跃的季节,但对于南方地区温度来说,还是会有存在的可能性。而狗狗又是需要每天出门溜,则更需要定期驱虫和检查,以防感染。